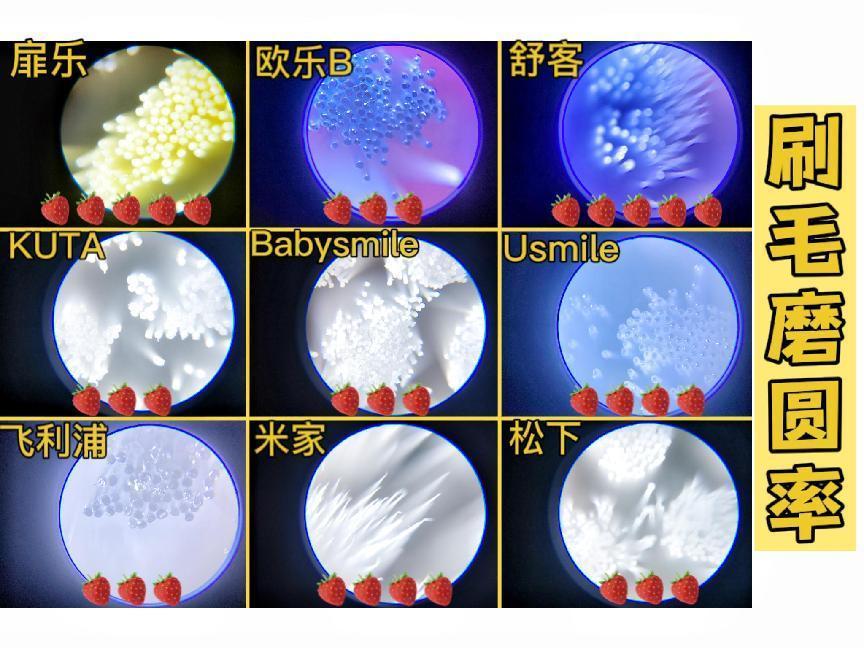
U型儿童电动牙刷测评排行榜,10-15岁儿童电动牙刷推荐测评

我国儿童的蛀牙率已经高达70.9%,因此儿童口腔养护问题需要家长格外重视。作为一名任职了三年的儿童电动牙刷产品工程师,儿子刚到三岁的时候,我就为他选择了儿童电动牙刷作为养护口腔的工具,并且监督他每天坚持使用,所以对于儿童电动牙刷怎么选的话题太有资格跟大家聊聊了。
出于职业原因,我在选购儿童电动牙刷的过程中对比了市面上很多不同的型号和品牌,发现很多网红品牌和跨界品牌并不具备专业的研发团队,缺少口腔护理经验,设计出的产品缺乏核心参数的调校与优化,这样的后果非常严重,非常容易伤害孩子的牙齿,甚至影响口腔发育。

加上我身边越来越多朋友问我儿童电动牙刷怎么选的问题,所以,我用了两个月的时间规划了本期儿童电动牙刷测评,希望可以利用内行人的选购逻辑以及严谨的测评数据教会各位家长儿童电动牙刷怎么选。
阅读指引
1.儿童电动牙刷测评优秀机型推荐
2.儿童电动牙刷测评
2-1 清洁力
2-2 磨损度
2-3 刷头选择
2-4 刷头综合细节(刷头尺寸、软硬度、磨圆率)
2-5 售后服务
3.儿童电动牙刷实用选购技巧
一、儿童电动牙刷测评优秀机型推荐
对于儿童电动牙刷选购比较有经验的家长,可以直接对比参考下面三支在儿童电动牙刷测评中表现比较好的品牌,新手家长则建议详细阅读全文。
高容错不伤牙的专业品牌:扉乐VIIV

扉乐是国内唯一专业不伤牙的品牌,前身为各大品牌提供数据和技术支撑,拥有多年口腔护理和技术调教经验。扉乐儿童电动牙刷主打“高容错+不伤牙”,凭借品牌为复杂国民口腔专研的八大不伤牙黑科技,可以在实现超高清洁度的同时每次刷牙降低90%损伤,解决了孩子就算是刷牙方法错误也不会伤牙的问题,所以儿子用扉乐刷牙我一直很放心。
除了不伤牙的技术以外,扉乐最大的不同是针对不同儿童牙齿阶段进行严谨的独家全链式六型分段护理,使用这种护理方式的业内只有扉乐一家,3种模式+4种刷头的设计可以适配3岁至15岁的超大年龄跨度,另外马达和刷头这种核心材质直接比肩千元水准,售后直接送5年刷头+7天试用+2年质保,性价比真的太高了。
适合幼龄儿童的柔软刷毛:舒客F2

舒客前期以牙膏产品出身,电动牙刷是品牌后续开发的延伸类目,国产老品牌的质量可以放心。舒客儿童电动牙刷的机身使用ABS材质打造,相当坚固耐摔,同时电动牙刷的刷毛材质非常柔软,加上震频和摆幅微弱,这种设计虽然不会对口腔造成过度磨损,但是也牺牲了相当一部分的清洁力,更适合幼龄儿童呵护口腔。
适合青少年的较强清洁力:飞利浦HX6322

飞利浦是非常有名的国际大品牌,售卖品类非常齐全,儿童电动牙刷是众多产品中的一个分支。这支儿童电动牙刷清洁力非常强大,几乎没有什么死角,但是震感很强,刷毛偏硬,并且磨圆率不是十分理想,对牙齿的健康程度要求很高,所以比较适合12岁以上的牙齿比较耐受的青少年使用
二、儿童电动牙刷测评
做了这么多年儿童电动牙刷的产品经理,我对于很多产品宣传与实际不符的现象已经司空见惯了,所以我本期测评的重点在于实际使用的清洁效果和使用舒适度的对比,而不是一味对比商家宣传的那些参数信息,真金还是假金,一试便知。
儿童电动牙刷测评品牌型号:

儿童电动牙刷测评第一维度:清洁力
儿童电动牙刷的清洁力非常重要,只有将口腔清洁到位才能有效预防蛀牙的发生,很多品牌都宣扬自家产品的超强清洁力,但是实际效果要么因为刷头尺寸太大无法深入死角,要么因为震动摆幅微弱,导致清洁效果往往不理想。
电动牙刷清洁力受动力长期衰减度、摆幅角度偏差值、刷毛裁剪和植毛细节数据等多项参数调校的综合影响,所以儿童电动牙刷怎么选?只有能够对电动牙刷数据做到精细的调校测试的品牌才能做到实现高清洁力的同时不伤牙。
我把巧克力分别涂在牙齿模型上,静置十分钟后用电动牙刷的清洁模式对牙齿模型进行两分钟的清洁。

测评结果分析:
★★★★★/飞利浦、欧乐B、扉乐
清洁度最好的是飞利浦、欧乐B和扉乐,牙齿表面和牙齿的缝隙以及牙窝沟的位置都可以清洁的很干净,但是使用的时候,可以对比出舒适度的不同。
欧乐B和飞利浦是依托于强烈震感和偏硬刷毛形成的巨大摩擦力来达到清洁效果,会对孩子的牙齿造成较大磨损,扉乐则是综合了独创的核定震频技术与稳定均匀的摆幅,保证清洁力的同时又能够保证刷牙的舒适。
★★★★/usmile、松下、小米
usmile、松下、小米清洁力还可以,只是牙齿咬合面有一定残留,如果延长刷牙时间,注意刷牙角度,清洁度应该还能得到提升。松下的刷头过大,小米的震频偶尔不稳定,Usmile后续动力不足,这些都影响了清洁力表现。
★★★/舒客、KUTA
KUTA和舒客的清洁力非常普通,窝沟咬合面有非常明显的残留。舒客的震感和摆幅偏微弱,KUTA的刷头偏大,所以清洁力受到很大限制。
★★/Babysmile
Babysmile的清洁力和手动牙刷没有太大的差别,电动牙刷的刷毛非常柔软和震感十分微弱,各个盲区留有明显的痕迹,当然Babysmile的产品定位就是三岁以下幼龄儿童,呵护为主,因此清洁力低可以理解。
儿童电动牙刷测评第二维度:磨损度
孩子的口腔比成年人脆弱,儿童电动牙刷需要表现出更低的磨损度,并且,不同的乳牙恒牙时期口腔环境发育变化快,口腔对磨损度的最低要求也不同,因此在评估清洁力的同时我们也要评估电动牙刷对口腔的磨损度。
儿童电动牙刷怎么选?很多家长单一的认为磨损度完全在于刷毛柔软与否,这是非常严重的误区。电动牙刷的磨损度与马达震动的均衡稳定性,刷毛材质、磨圆、柔软度等核心参数综合相关,需要考究的细节非常全面。
我用湿纸巾模拟牙齿表面,分别用不同电动牙刷的清洁档位对湿纸巾进行三十秒的清洁,观察清洁完成后纸巾的磨损程度。

测评结果分析:
★★★★★/扉乐、舒客、babysmile
扉乐、舒客和Babysmile的护牙力都非常高。扉乐研发了八大不伤牙黑科技,湿纸巾几乎没有磨损,只有微微的痕迹,不仅清洁力好还能做到那么低的磨损度,确实很专业。舒客和Babysmile的设计方向偏于呵护,刷毛较软,震感摆幅微弱,所以磨损度比较低,但这也是牺牲了清洁力的表现。
★★★★/KUTA
KUTA的磨损相对较少,刷毛表现也比较柔软,只是震感稍强,刷头尺寸跟成人差不多大,对口腔造成了一定的磨损。
★★★/Usmile
Usmile的磨损度就有较大提升空间了,电动牙刷的刷毛偏硬,磨圆率有待提升,比较容易对牙齿造成磨损。
★★/欧乐B、飞利浦、松下、小米
欧乐B、飞利浦、松下的护牙力相对较低,欧乐B、飞利浦的刷毛偏硬,震感剧烈,很容易对孩子的牙齿造成磨损,小米和松下的动力调教不稳定,再加上松下磨圆率不理想,伤牙风险极高,建议12岁以上牙齿耐受好的青少年选择。
儿童电动牙刷测评第三维度:刷头选择
孩子的口腔处于动态发育变化中,不同年龄的孩子由于口腔发育的阶段不同,口腔状态也完全不一样,就算是同样发育阶段的孩子也会因为饮食习惯和牙齿素质差异,对儿童电动牙刷的要求有所不同。儿童电动牙刷怎么选?这就需要品牌设计不同的刷头来匹配儿童不同的口腔阶段,实现人群兼容匹配度的最大化。

测评结果分析:
4种/扉乐
扉乐配备了四种刷头,不同选择有不同的刷毛硬度、刷毛细节等针对性设计,能够满足孩子牙齿生长发育阶段的全年龄段覆盖使用,并且扉乐还搭配了力度跨度变化很大的三种模式,难怪敢宣称兼容3-15岁。
2种/Usmile、松下
Usmile和松下有两种刷头,Usmile的刷头主要是尺寸和颜色变化,其他的植毛率和软硬度变化不大,选择相对局限,松下的两种刷头只有一种能够用来日常清洁,另一种是专对牙缝清洁设计的刷头,实际对刷牙意义不大,当然了也比1种刷头好很多了。
1种/欧乐B、飞利浦、舒客、小米、Babysmile、KUTA
欧乐B、飞利浦、舒客、小米、Babysmile、KUTA只配备了一种刷头,年龄的匹配度非常低,要么只适合幼龄儿童,要么只适合大一点的孩子,不太能适应所有年龄段不同牙齿状态的孩子使用。
儿童电动牙刷测评第四维度:刷头综合细节
刷毛的综合细节表现是决定电动牙刷舒适度和清洁度的重要因素,需要从刷毛的材质应用、刷毛软硬、磨圆情况、形状设计是否科学、是否能实现对牙齿的较好包裹性等进行整体评估,我选择了比较重要的刷头尺寸、磨圆率和软硬度进行测评。
刷毛细节1:刷头尺寸
儿童电动牙刷的刷头最好比较小巧,刷头过大很难在孩子娇小的口腔中灵活转动,容易存在清洁死角。儿童电动牙刷怎么选?刷头大小最好与一颗牙齿差不多宽,与一至两颗牙齿差不多长。我用游标卡尺量出每支电动牙刷的刷头长度和宽度,对比刷头大小。

测评结果分析:
刷头较小/欧乐B、Babysmile、扉乐
欧乐B、扉乐和Babysmile的刷头比较小,能够深入牙齿缝隙和后槽牙部位,完成深度的清洁。前面我也提到了扉乐提供四种刷头,测评中也发现适合八岁以上儿童的刷头大小适中,适合幼儿的刷头设计就相对迷你,能够实现不同口腔发育阶段的覆盖跨度。
刷头适中/扉乐、Usmile、舒客
扉乐青少年刷头、Usmile、拜尔、舒客的刷头大小适中,比较符合标准尺寸的要求。
刷头较大/KUTA、飞利浦、小米
KUTA、飞利浦、小米的刷头比较大,跟部分成人牙刷相差无几,容易造成清洁盲区,同时容易加重磨损。
刷毛细节2:软硬度
孩子的口腔是一直在发育变化的,刷毛软硬也需要根据不同口腔发育阶段的要求来变化,不能一直使用过软或者过硬的刷毛。儿童电动牙刷怎么选?幼龄儿童适合偏软的刷毛,刷牙目的以呵护为主,清洁为辅,八岁以上的孩子就可以选择适中偏软刷毛,不但能够全面清洁口腔,同时还能更好呵护牙齿牙龈。我电动牙刷刷毛按在桌子上,刷毛弯曲越大,刷毛越软。

测评结果分析:
偏硬/飞利浦、欧乐B、Usmile
飞利浦、欧乐B、Usmile的刷毛对于少儿来说实在是偏硬了,如果调整柔软一点可能综合体验会更好。
偏软/舒客、扉乐、拜尔、Babysmile、小米
舒客、拜尔、Babysmile、小米的刷毛偏软,幼儿用起来会比较放心,但是对于年纪较大的孩子可能较难达到清洁效果。扉乐四种刷头的刷头不仅调节了大小,还调节了软硬,适合幼龄儿童的刷头软硬偏软,适合八岁以上儿童设计的刷头适中偏软。
适中偏软/KUTA、扉乐
前面说了,扉乐青少年版刷头适中偏软,能够兼顾青少年牙齿的清洁,KUTA的刷毛同样适中偏软,比较适合年纪较大的孩子使用,不过可惜kuta刷毛的磨圆率和尺寸做得有待提升,所以对青少年的护牙率也有待提升。
刷毛细节3:磨圆率
刷毛磨圆率是影响舒适度和安全性的重要因素,磨圆率越高,孩子刷牙体验会更加温和舒适。但磨圆率概念比较专业,需要耗费很多的时间进行精细打磨和反复测试,肉眼还无法看见磨圆程度,所以很多品牌都不会标注磨圆率,儿童电动牙刷怎么选?磨圆率越高的品牌,越值得信任。我把电动牙刷的刷毛放在显微镜下放大一百倍,对比不同牙刷的磨圆状态。
测评结果分析:
★★★★★/舒客、扉乐
扉乐、舒客的磨圆率非常高,刷毛的尖部经过无数次的打磨,呈现出光滑的球形,可见对牙齿的保护程度比较高。
★★★★/小米、Usmile
Usmile的磨圆率还可以,但是Usmile的刷毛过硬了,改进一下会有更好的表现,小米的刷毛属于细软刷毛,无法观察磨圆率,但单纯感受刷毛体验尚可。
★★★/飞利浦、欧乐B、KUTA、松下、Babysmile
飞利浦、欧乐B、KUTA、松下、Babysmile的磨圆率都比较低,可以明显的看到这几支电动牙刷的刷毛呈现出近乎平形的切面,尖部非常锋利,很有可能对牙釉质和牙龈造成磨损,幼龄儿童慎选。
儿童电动牙刷测评第五维度:售后服务
孩子在学习使用电动牙刷的过程中,很有可能因为操作不当造成电动牙刷的损坏或者刷毛的频繁炸裂,所以电动牙刷的售后也是比较重要的参考依据,重点关注质保年限、是否支持试用和刷头替换成本,我都列举在下面了,大家自行对比,我就不再过多阐述了。

三、儿童电动牙刷实用选购技巧
作为产品工程师,我为儿子选儿童电动牙刷一定会按照全面清洁+绝对不伤牙的两大原则评估电动牙刷的性能,但是市面上的品牌技术实力差异较大,很难做到两者兼顾,特别是最重要的不伤牙。儿童电动牙刷怎么选?我总结了十个重要的参考技巧,家长可以收藏起来反复对比。
技巧一:评估品牌的技术实力
尽可能选择专业品牌。专业的品牌不仅拥有丰富口腔护理经验,还能够针对市面上普遍儿童电动牙刷兼容性差、舒适度差、伤牙率高等问题进行专业的技术解决和优化。所以,专业品牌研发的产品,震动频率的偏差值、动力强度的长期衰减度、摆幅的均匀性等几十项参数表现都要优于劣质电动牙刷80%至90%,部分有技术实力的品牌还能做到电动牙刷绝对不伤牙,全面保护孩子的口腔健康,这是网红品牌和跨界品牌普遍做不到的。

技巧二:注意摆幅的角度设计
儿童的口腔比较娇小稚嫩,所以儿童电动牙刷的摆幅最好控制在3度至6度内,这样才能实现高清洁力的同时不容易磨损牙齿牙龈。
技巧三:拒绝低价的劣质产品
家长一定不要因为图便宜去选购低价电动牙刷。这种电动牙刷普遍使用空心杯马达,随意选择材质极差的刷毛,导致电动牙刷震感忽强忽弱,动力非常不稳定,刷毛磨圆细节极差,使用后一定会造成伤牙后果,得不偿失。

技巧四:一定不买U型儿童牙刷
专家实验表明,U型牙刷的硅胶刷毛和微弱摆幅震动,导致清洁能力非常低,不仅无法实现全面清洁,三面环形设计还会导致硅胶刷毛磨损牙龈的时候同时作用三个面,实际加重磨损更伤牙。

技巧五:注意产品的兼容匹配度
孩子的口腔处在动态发育阶段,从乳牙萌出到乳牙牙根发育再到恒牙替换和恒牙发育阶段的变化非常复杂,只有震频力度变化跨度大、模式和刷头选择丰富的儿童电动牙刷才能兼顾孩子的口腔发育变化。
很多品牌宣称产品能够让孩子用到十五岁,实际上只是简单的把三岁至十五岁的儿童粗暴划分为大小儿童,完全做不到专业细分,所以看到宣传3岁至15岁可用却只有2种模式+1种刷头的就可以果断拒绝了。

技巧六:选择优质的磁悬浮马达
优质的磁悬浮马达相比空心杯马达,不仅震动稳定,结构精密,而且还能够保证电动牙刷在不同的震动频率、摆幅下单次持续平衡度和均匀性足够高,长期衰减度足够低,提高牙刷的整体综合性能。
技巧七:选择优质的刷毛材质
刷毛材质优先选择舒适度较高,包裹性和支撑性好的优质杜邦刷毛,可以更好的清洁牙齿,保护孩子口腔健康。
技巧八:仔细对比刷头的尺寸
刷头的尺寸非常影响清洁效果,孩子的口腔本身就比较小,偏小的刷头可以灵活的在口腔内转动,不容易形成刷牙盲区。另外,儿童电动牙刷的刷毛长度能够覆盖 1颗至2 颗牙齿,宽度能够覆盖最大的一颗牙齿是最佳的。

技巧九:考虑刷头寿命和替换成本
根据使用的情况,儿童电动牙刷的刷头一般2至3个月就要进行更换,但是孩子的学习能力和手部力量比成人低,学习刷牙的期间难以把握刷牙力度和角度,导致刷毛分叉、毛躁、弯曲的概率比成人牙刷大很多,所以刷头替换频率也会随之变高。所以,为孩子选购电动牙刷的时候要考虑刷头替换成本,需注意的是有很多品牌甚至都没有替换刷头可购买,简直是一次性产品,性价比非常低。

技巧十:注意手柄的舒适握持感
孩子对于电动牙刷的手握感非常关键,很多儿童电动牙刷的手柄设计非常粗大,孩子拿在手上很难控制刷牙力度和角度,抓握起来还会增加孩子刷牙的疲惫感。这里友情建议家长优先考虑可以试用的品牌,先买回来让孩子试一下手感和是否容易刷牙出血,觉得合适再留下,不合适还可以退货,避免浪费。
孩子的牙齿养护是长期并且需要付出耐心教导的过程,家长们要从小教会孩子科学刷牙的方法,全面预防蛀牙,才能打下良好的牙齿素质基础,减少日后牙齿患病的概率。希望本期儿童电动牙刷测评可以教会大家儿童电动牙刷怎么选,帮助家长擦亮眼睛,选到真正有实力的品牌。